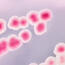

50 Euro Zuschuss für alternative Arzneien
Bei einer leichten Erkältung, Kopfschmerzen oder Problemen mit dem Magen nutzen viele natürliche Arzneien. Wir unterstützen Sie bei den Kosten mit einem jährlichen Budget von bis zu 50 Euro. Das Budget gilt für natürliche Arzneimittel der Phytotherapie, Anthroposophie und Homöopathie aus der Apotheke.
Wichtig dabei: Ihre Arztpraxis verschreibt Ihnen die Arznei auf einem privaten Rezept und Sie lösen es in der Apotheke ein. Reichen Sie uns für die Erstattung einfach das Privatrezept zusammen mit der Apotheken-Rechnung ein.
Was sind Arzneien der Phytotherapie, Anthroposophie und Homöopathie?
- Natürliche Arzneimittel aus der Pflanzenheilkunde (Phytotherapie) sind beispielsweise ätherische Öle, Trockenextrakte, Tinkturen, Wurzeln und Blätter.
- Anthroposophie bedeutet übersetzt: Weisheit des Menschen. Zu den Arzneimitteln aus der Anthroposophie zählen mineralische, metallische oder pflanzliche Substanzen.
- Homöopathische Medikamente sind mehrfach verdünnte Substanzen. Sie bekommt man als Lösungen, Tabletten oder kleine Kügelchen, sogenannte Globuli.
@adobestock_winyu